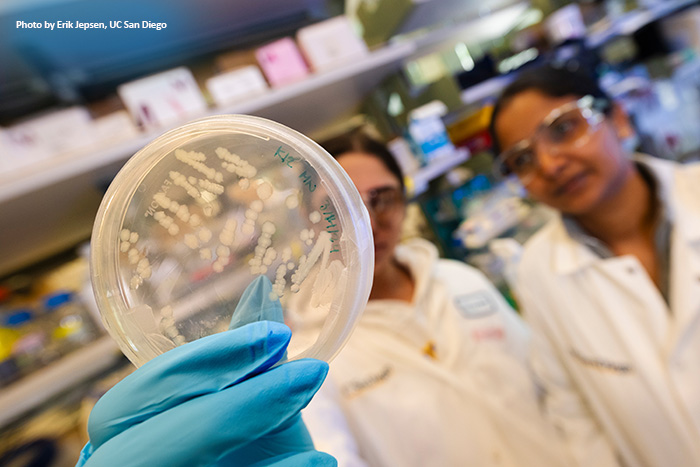

With spring underway, we're excited to share that, because of your generosity,
Propel a Cure will soon help launch another promising research project
focused on the causes of Crohn's disease.
With spring underway, we're excited to share that, because of your generosity,
Propel a Cure will soon help launch another promising research project
focused on the causes of Crohn's disease.
Your support plays a vital role in advancing early-stage studies that
might not otherwise get off the ground.
By funding bold, innovative ideas,
you are helping researchers explore new concepts that deepen our understanding
of Crohn's and lay the groundwork for future cures.
Time and again, projects
supported by Propel a Cure go on to secure significantly larger funding
as they advance to later stages, amplifying the impact of your giving.
Stay tuned for the announcement of our next $100,000 Trailblazer Grant
recipient, coming this summer! In the meantime, we invite you to read below
about how two schools in the greater Chicago area stepped up to make a
meaningful difference in Crohn's research—and helped make this upcoming
grant possible.
|

|
YOUNG CHANGEMAKERS RAISE
MAJOR FUNDING TO FUEL RESEARCH
|
A big shout-out to Highland Park High School (HPHS) and Edgewood Middle School (Highland Park, IL) for their recent gift of
$121,463.94
to Propel a Cure, the single largest donation in the organization's history!
Vice President Tracy Loewenthal, seen above accepting the big check, served as Propel a Cure's liaison for the HPHS annual charity drive, which generated this funding.

Last fall, Propel a Cure was selected as the beneficiary of the initiative by students, faculty, and staff. Throughout
January and February, a student-led committee organized numerous fundraising
events, from a chili cook-off and cannonball contest to a 24-hour run,
with all proceeds supporting Crohn's disease research.

Edgewood Middle School, a feeder school to HPHS,
held its own drive in March, contributing more than
$18,200
to the grand total.
|
|
SPONSORED PROJECT UPDATES
|
|
UC SAN DIEGO STUDY REFRAMES CROHN'S
AS "FAILED INFECTION CONTROL"
|
Since our last update in the previous newsletter, there has been a major
advance in the Propel a Cure-sponsored project at the
Ghosh Lab
and Institute for Network Medicine at UC San Diego. Earlier work (published
in
The Journal of Clinical Investigation
showed that a partnership between
NOD2
(the strongest Crohn's risk gene) and
GIV
(CCDC88A)
is essential for macrophages to both clear microbes and control inflammation.
When this partnership fails—as in Crohn's-associated NOD2 mutations—immune
cells become activated but ineffective, allowing microbes to persist and
inflammation to become chronic.
A new
preprint
(a manuscript that has been submitted to a journal and is awaiting peer
review) reveals
how this failure unfolds in real time.
The key insight is that immune defense depends on a precisely timed
"surge-to-plunge" program
in cyclic AMP (cAMP), which is a type of rapid-fire messaging system in
our bodies:
-
An early surge tempers inflammation
-
A subsequent plunge is required for macrophages to kill microbes through
phagolysosomal fusion, a cell's only way to eliminate threats or waste.
Many pathogens encountered in Crohn's disease exploit this system by sustaining
high cAMP, effectively disabling the cell's killing machinery.
This study shows that the NOD2–GIV partnership acts as a molecular toggle
switch that enforces this timing. NOD2 first binds GIV to allow the early
cAMP rise; GIV then switches to engage G proteins (a type of molecular
switch), actively collapsing cAMP to enable microbial clearance. This tightly
timed, structurally encoded switch functions as a decision-making circuit
within immune cells. When the toggle fails, cAMP remains high, directly
leading to downstream signals to remain hyperactive so that macrophages
can ingest—but not destroy—bacteria. Infection persists, barrier integrity
breaks down, and inflammation becomes self-sustaining.
Importantly, the mechanistic insights gained make a compelling case that
two clear entry points emerge for
treating
Crohn's disease:
Upstream:
Restore or stabilize the NOD2–GIV toggle (e.g., via molecular "glues"
that reconstitute the interaction).
Downstream:
Target the cAMP and its immediate signaling pathway to re-enable microbial
clearance.
Conceptually, this reframes Crohn's disease from an overactive immune
state to one of failed infection control and explains why antibiotics used
in the treatment of Crohn's disease have not worked as well as they should
have, because pathogens find safe havens within our immune cells that should
have killed them otherwise.
|
|
|

|
TEAM MANIPULATES SULFIDE LEVELS
WITH ENGINEERED BACTERIA
|
Thanks to the Mendez Family Foundation and other Propel a Cure donors,
researchers at Northeastern University's
Woolston Lab
continue to make progress toward better understanding the possible role
of the molecule hydrogen sulfide – produced primarily by gut microbes –
in the intestinal inflammation seen in inflammatory bowel disease (IBD).
Previously, the team has experienced promising results in using specially
engineered bacteria to deliver sulfide to mice. They have now begun testing
strains that are engineered to sequester (remove) excess sulfide in the
mice. The idea would be to bring sulfide levels back down to a healthy
balance when they get too high, as higher levels have been associated with
inflammation.
Experiments are still continuing and need to be repeated to establish
robustness and statistical significance, but preliminary results have been
encouraging. Mice that have been given the engineered bacteria have shown
lower sulfide levels compared to mice that have received the control strain
without the special modification.
Researchers have also been busy drafting the study's results from previous
quarters for submission to an academic journal in the near future.
|
|
|

|
MORE THAN A DIAGNOSIS:
ENGINEERING HOPE THROUGH CROHN'S
|
Blake Owens is the CEO and co-founder of
Fathom, one of Propel a Cure's corporate sponsors. Fathom is home to an AI-powered
wellness companion designed specifically for IBD patients. A software engineer,
Blake developed the app after being diagnosed with Crohn's disease two
years ago.
 Reflecting on his Crohn's journey, Blake says, "I'm 37 and was diagnosed
at 35, though I struggled on and off throughout my 20s and suspected IBD.
Around the time of my diagnosis, I found it increasingly difficult to self-manage.
Years of Crohn's issues had caused a stricture from repeated scarring,
which made eating very difficult. Long story short, after about 18 months
of alternating between significant weight loss from difficulty eating and
temporary relief from steroids, I ended up in the hospital needing a small
bowel resection and a temporary ileostomy to help recovery."
Reflecting on his Crohn's journey, Blake says, "I'm 37 and was diagnosed
at 35, though I struggled on and off throughout my 20s and suspected IBD.
Around the time of my diagnosis, I found it increasingly difficult to self-manage.
Years of Crohn's issues had caused a stricture from repeated scarring,
which made eating very difficult. Long story short, after about 18 months
of alternating between significant weight loss from difficulty eating and
temporary relief from steroids, I ended up in the hospital needing a small
bowel resection and a temporary ileostomy to help recovery."
At the time of his diagnosis, Blake says that he was already part of the
tech space and that AI was increasingly becoming a bigger part of his world.
He began using AI to learn more about his disease and help manage his diet.
With his stricture, AI helped make exploring a low-fiber, low-residue diet
a little more manageable. He stresses that he understands AI's shortcomings
and used it only as a source of suggestions – not a source of truth – and
always consulted his healthcare team when making decisions. It was during
this time that he started exploring the current app landscape and developing
the idea for Fathom.
Blake founded Fathom with his friend Jon Hargreaves, a product designer.
They designed the app to accommodate each patient's customized health profile,
incorporating morning and evening check-ins, symptom tracking, and weekly
overviews. In the future, they hope to add additional tracking features,
as well as more robust historical charts and trends.
The company's commitment to giving back to the IBD community is clear.
According to Blake, "My co-founder Jon and I love and excel at building
technology and products. Therefore, finding the teams and organizations
that focus more on the people, community, and research was extremely important
to us. Since IBD is such a personal journey for me, my philosophy from
day one was simple: Focus on what I'm personally good at to make an impact,
and help others do what they're good at to make an impact."
He adds, "Beyond just aligning with their mission, working with Angela
and the team at Propel a Cure has been incredible since our first call.
We're eager and hopeful to continue supporting Propel a Cure as long as
we can!"
|
|
|

MEET OUR NEWEST PARTNERS
|
Propel a Cure is pleased to announce the expansion of its nonprofit partnership
network through new collaborations with Connecting to Cure Crohn's and
Colitis and TeamTenisa. These partnerships reflect a shared commitment
to supporting the IBD community and to amplifying the valuable resources
each organization provides.

Connecting to Cure Crohn's and Colitis
- In addition to funding IBD research, Connecting to Cure's CONNECTIONS
programs provide essential complementary and emotional support to the patient
and caregiver communities. Their CONNECTIONS initiatives encompass support
groups, mentorship programs, and restorative activities designed to manage
symptoms, optimize patient health, enhance patient and caregiver quality
of life, and connect with others.
 TeamTenisa
- This nonprofit is dedicated to honoring the memory of Tenisa E.M. Wallace
by advocating for greater awareness and understanding of Crohn's disease
and ulcerative colitis. They believe no one should face IBD in silence.
Their mission is to raise awareness of these invisible illnesses, share
real stories, and illuminate the daily struggles behind the smiles. Through
advocacy, education, and a whole lot of heart, they strive to build a more
informed, compassionate world – and push forward toward a cure.
TeamTenisa
- This nonprofit is dedicated to honoring the memory of Tenisa E.M. Wallace
by advocating for greater awareness and understanding of Crohn's disease
and ulcerative colitis. They believe no one should face IBD in silence.
Their mission is to raise awareness of these invisible illnesses, share
real stories, and illuminate the daily struggles behind the smiles. Through
advocacy, education, and a whole lot of heart, they strive to build a more
informed, compassionate world – and push forward toward a cure.
|

VIDEO INTERVIEW
NEW INSIGHTS, NEW HOPE FOR CROHN'S FISTULAS
|
As part of our ongoing video
interview series with leading IBD researchers, we spoke this past winter with Dr. Alison Simmons, whose team at Oxford University has made groundbreaking
discoveries about Crohn's-related fistulas, an extremely challenging disease
complication.
For the first time, these fistulas have been shown to be organized, living
structures lined with "rogue" fibroblasts that drive an abnormal wound-healing
response – an insight that could open new pathways for treatment and prevention.
|

DR. ALISON SIMMONS
|
Dr. Simmons, a member of Propel a Cure's
Scientific Advisory Board, is a clinician scientist who researches disease immunity. She has systematically
characterized the molecular pathogenesis of inflammatory bowel disease,
including work in molecular mapping that has highlighted novel avenues
for tackling unmet needs in tissue inflammation. She trained in medicine
and gastroenterology and is Director of Oxford's MRC Translational Immune
Discovery Unit and Professor of Gastroenterology at the university, as
well as a Fellow of the Academy of Medical Sciences.
Click
here
to watch the video.
|

INSIDE CROHN'S RESEARCH
A LIVE ROUNDTABLE FOR RECURRING DONORS
|
An exclusive IBD research roundtable designed especially for Propel a Cure recurring donors will take place on Thursday, May 14, at 1 p.m. EDT.
This live webinar will feature special guest Dr. Pradipta Ghosh, Professor of Medicine and Cellular and Molecular Medicine at the University of California, San Diego.
Propel a Cure is proud to support groundbreaking work led by Dr. Ghosh's lab: "Modification of Dysfunctional Sensing and Signaling in Crohn's Disease." This project is already generating international headlines with its findings.
During this interactive session, Dr. Ghosh will share an inside look at her team's latest research, including how disrupted communication between cells appears to drive the chronic inflammation and impaired bacterial clearance seen in Crohn's disease. She will also explore how this discovery is opening promising new pathways to restore normal immune function for patients.
Attendees will have the opportunity to engage directly with Dr. Ghosh during a live Q&A text chat. Those who register and are unable to attend will receive a recording for on-demand viewing.
Don't miss this important discussion. By becoming a Hope Builder recurring donor, you'll receive your personal invitation—along with ongoing access to insider research updates like this.
Visit propelacure.org/donate and choose the monthly, quarterly or annual giving option today to reserve your spot for May 14.
|

HOPE BUILDERS
ONGOING SUPPORT FROM RECURRING DONORS
|
Join our community of committed supporters and help accelerate the path to a cure. We are grateful to the following Hope Builder recurring donors for their support.
|
Raihaneh Bokharai
|
Gustavo Nonohay
|
|
Sue Cragg
|
Kathleen Pinckney
|
|
Vince Cvijanovic
|
Anthea Pritchard
|
|
Dina Fiatarone
|
Devin Rasmussen
|
|
Stephen Hall
|
Hellie Saffery
|
|
Tracy Loewenthal
|
Laskshmi Sampath
|
|
Diana Miguens
|
Misty Triplett
|
|
Natalie Muccioli
|
Eric Voisard
|
|

RESEARCH REVIEW
NEWS ABOUT CROHN'S & IBD
|
Broad Institute researchers have identified a rare gene variant called CARD9 as protective against IBD and are pursuing therapies that mimic its effect.
Article Link:
Broad Institute
|
Vanderbilt University scientists have discovered that different regions of the gut respond differently to inflammation and treatment and why.
Article Link:
Vanderbilt University
|
IBD doesn't just inflame the gut -- it rewires it by changing how nerves are arranged in the intestine, which in turn affects how intestinal muscles function. This discovery by UMass Chan Medical School researchers may help explain why some IBD patients continue to experience symptoms even while in remission.
Article Link:
UMass Chan Medical School
|
"French researchers have identified a distinct circulating viral community in patients with Crohn's disease (CD) that may serve as a disease signature. The findings published in Gastroenterology challenge the long-held assumption that blood is sterile and suggest that alterations in the circulating virome may reflect intestinal barrier dysfunction in CD."
Article Link:
Medscape
|
Thank you for your support!
|
Thank you for supporting
Propel a Cure! If you can get involved, please let us know. We would love to have you
as a volunteer!
If you'd like more information about Propel a Cure or have suggestions
for topics you'd like to see covered in the next newsletter, please contact
us at
info@propelacure.org.
Together we can make a difference!
|

ANGELA CLARK
President and CEO
|
|

info@propelacure.org
|
PropelaCure.org

|





